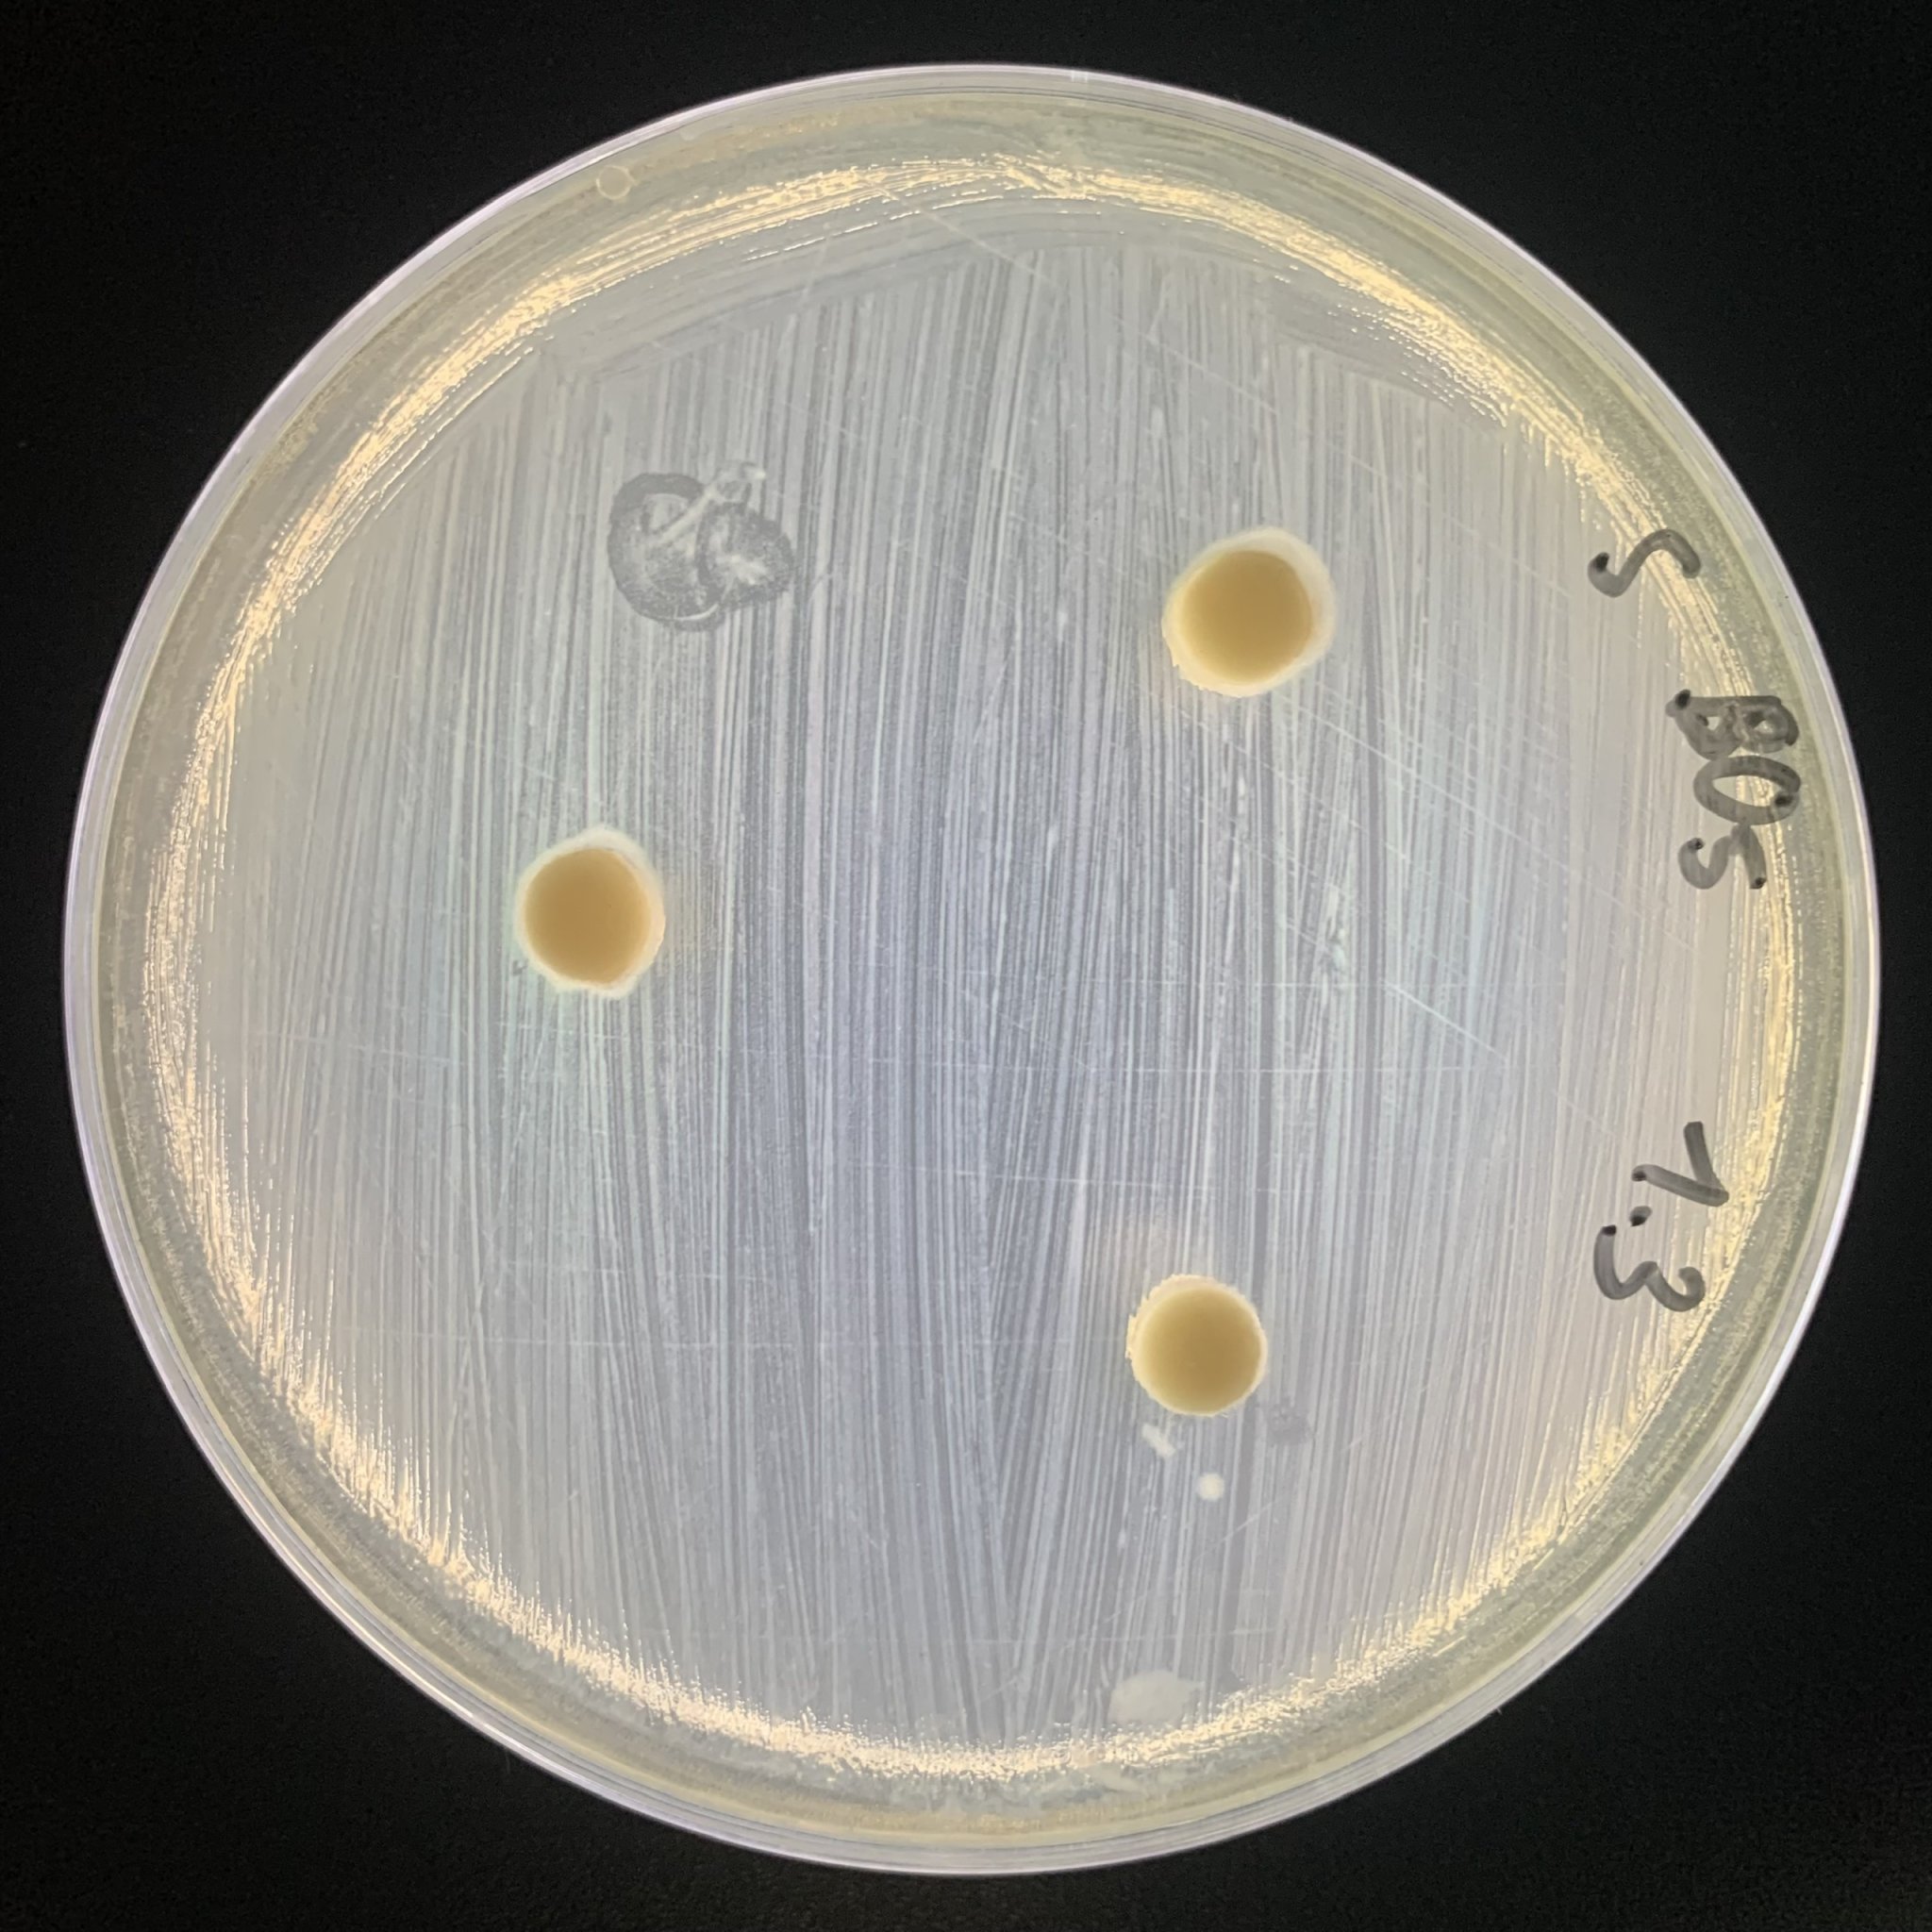
Bacillus clausii
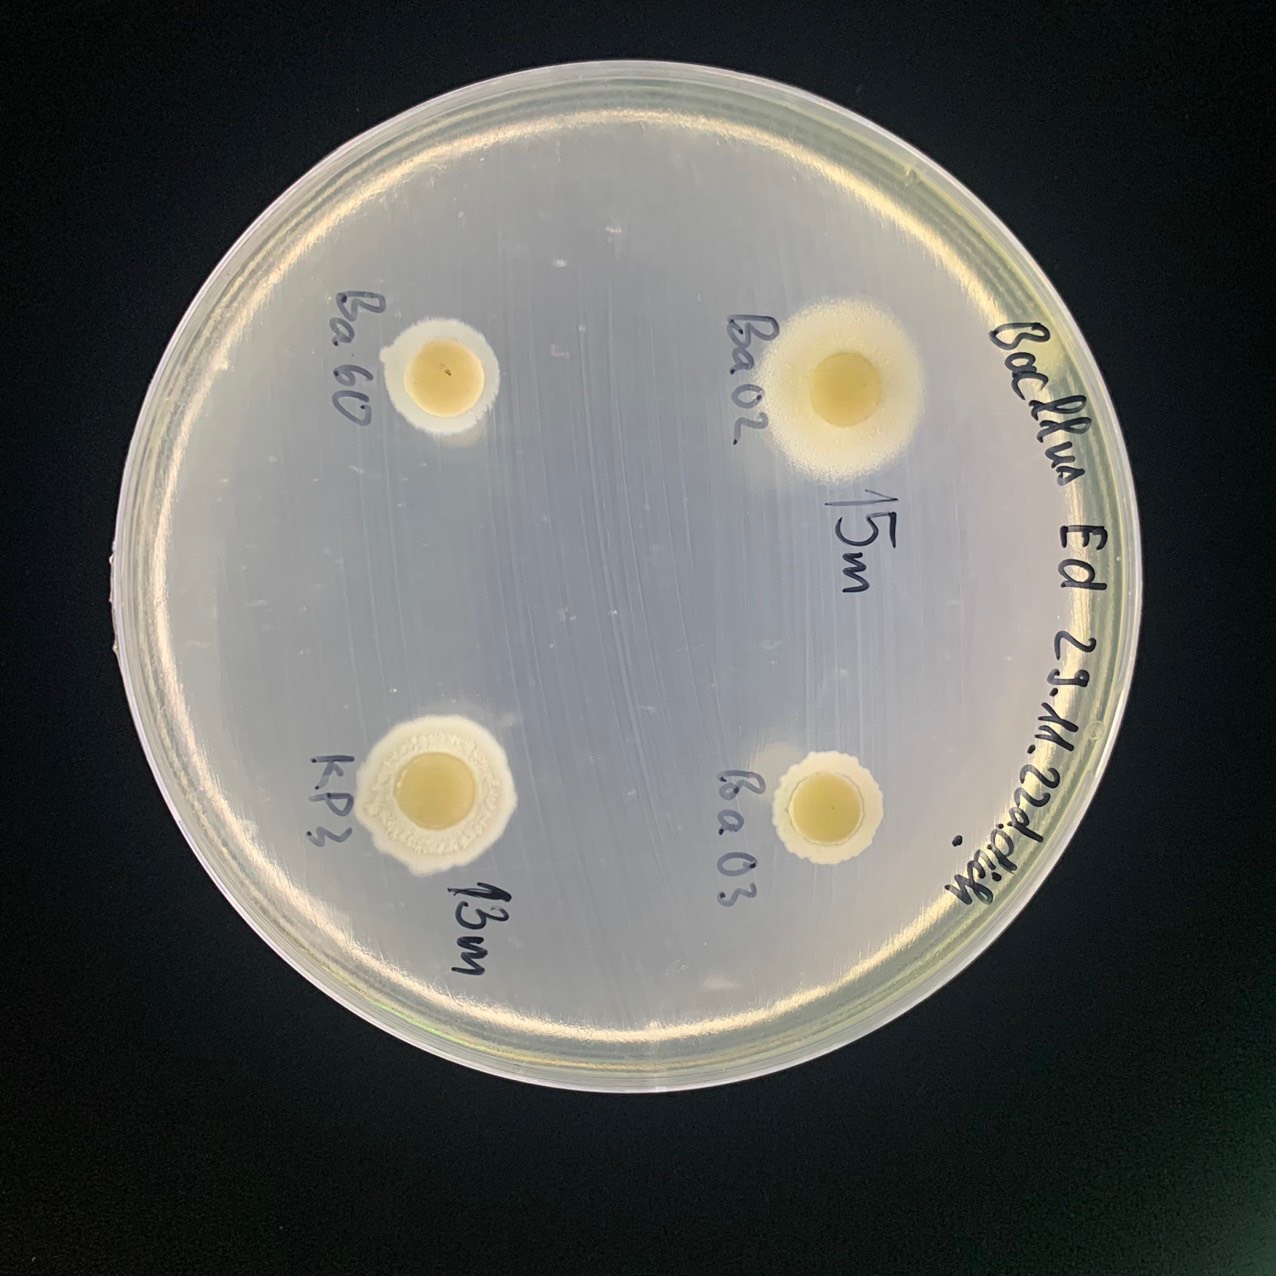
Bacillus licheniformis
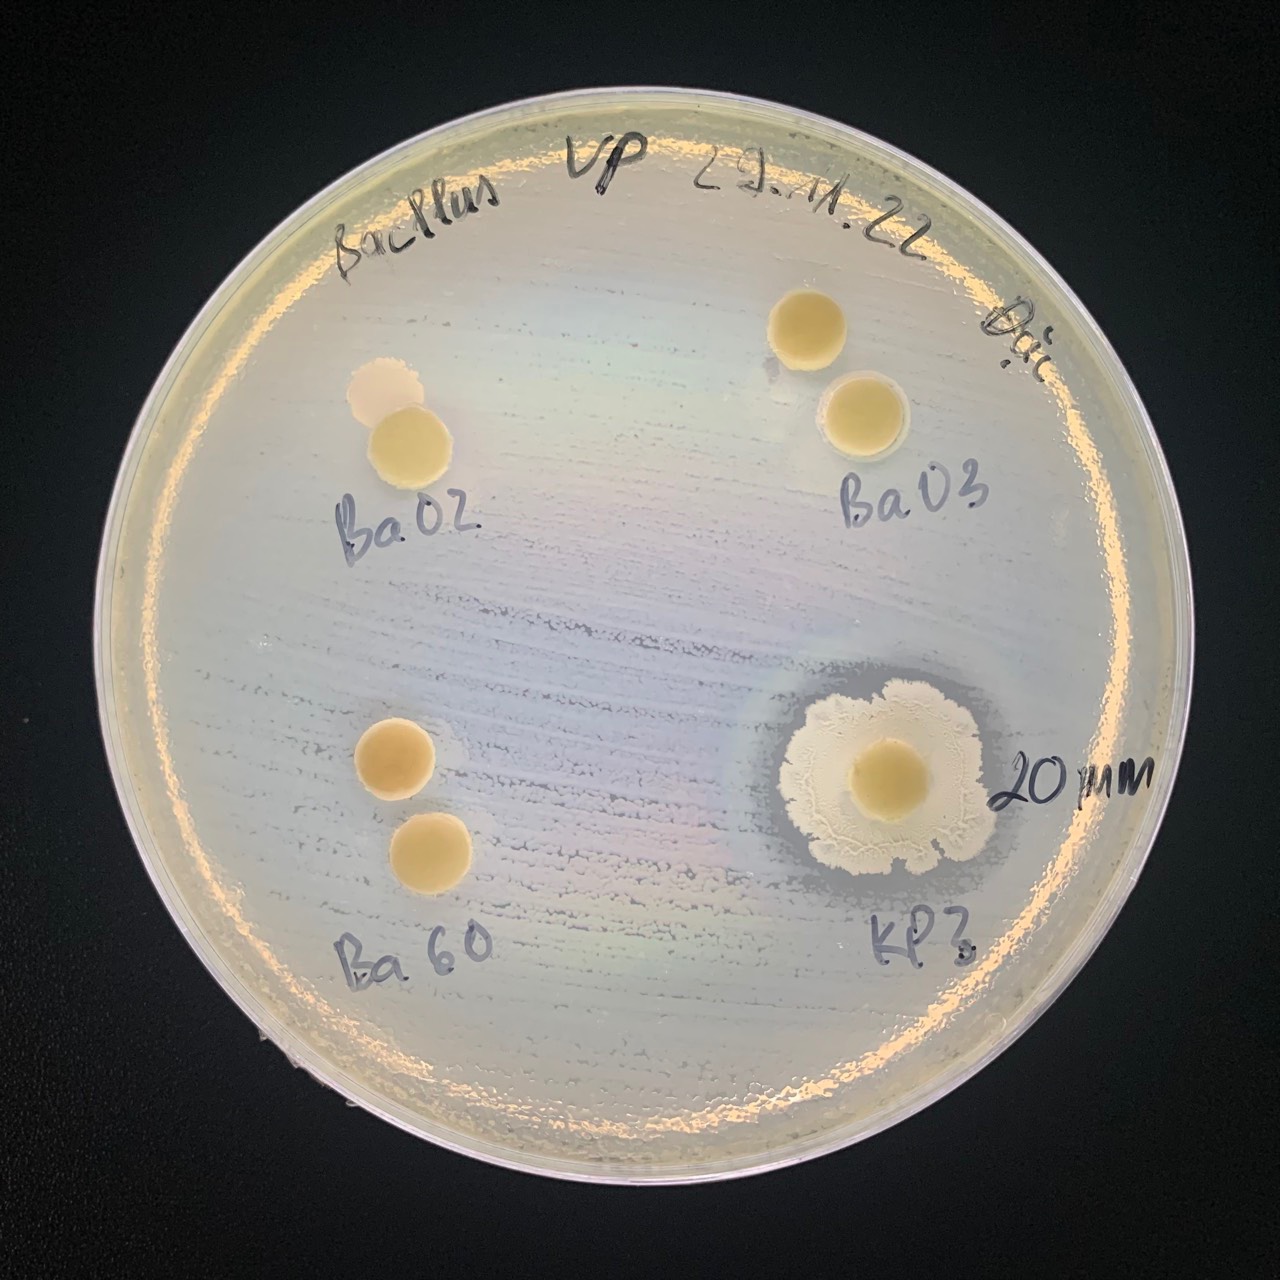
Bacillus amyloliquefaciens
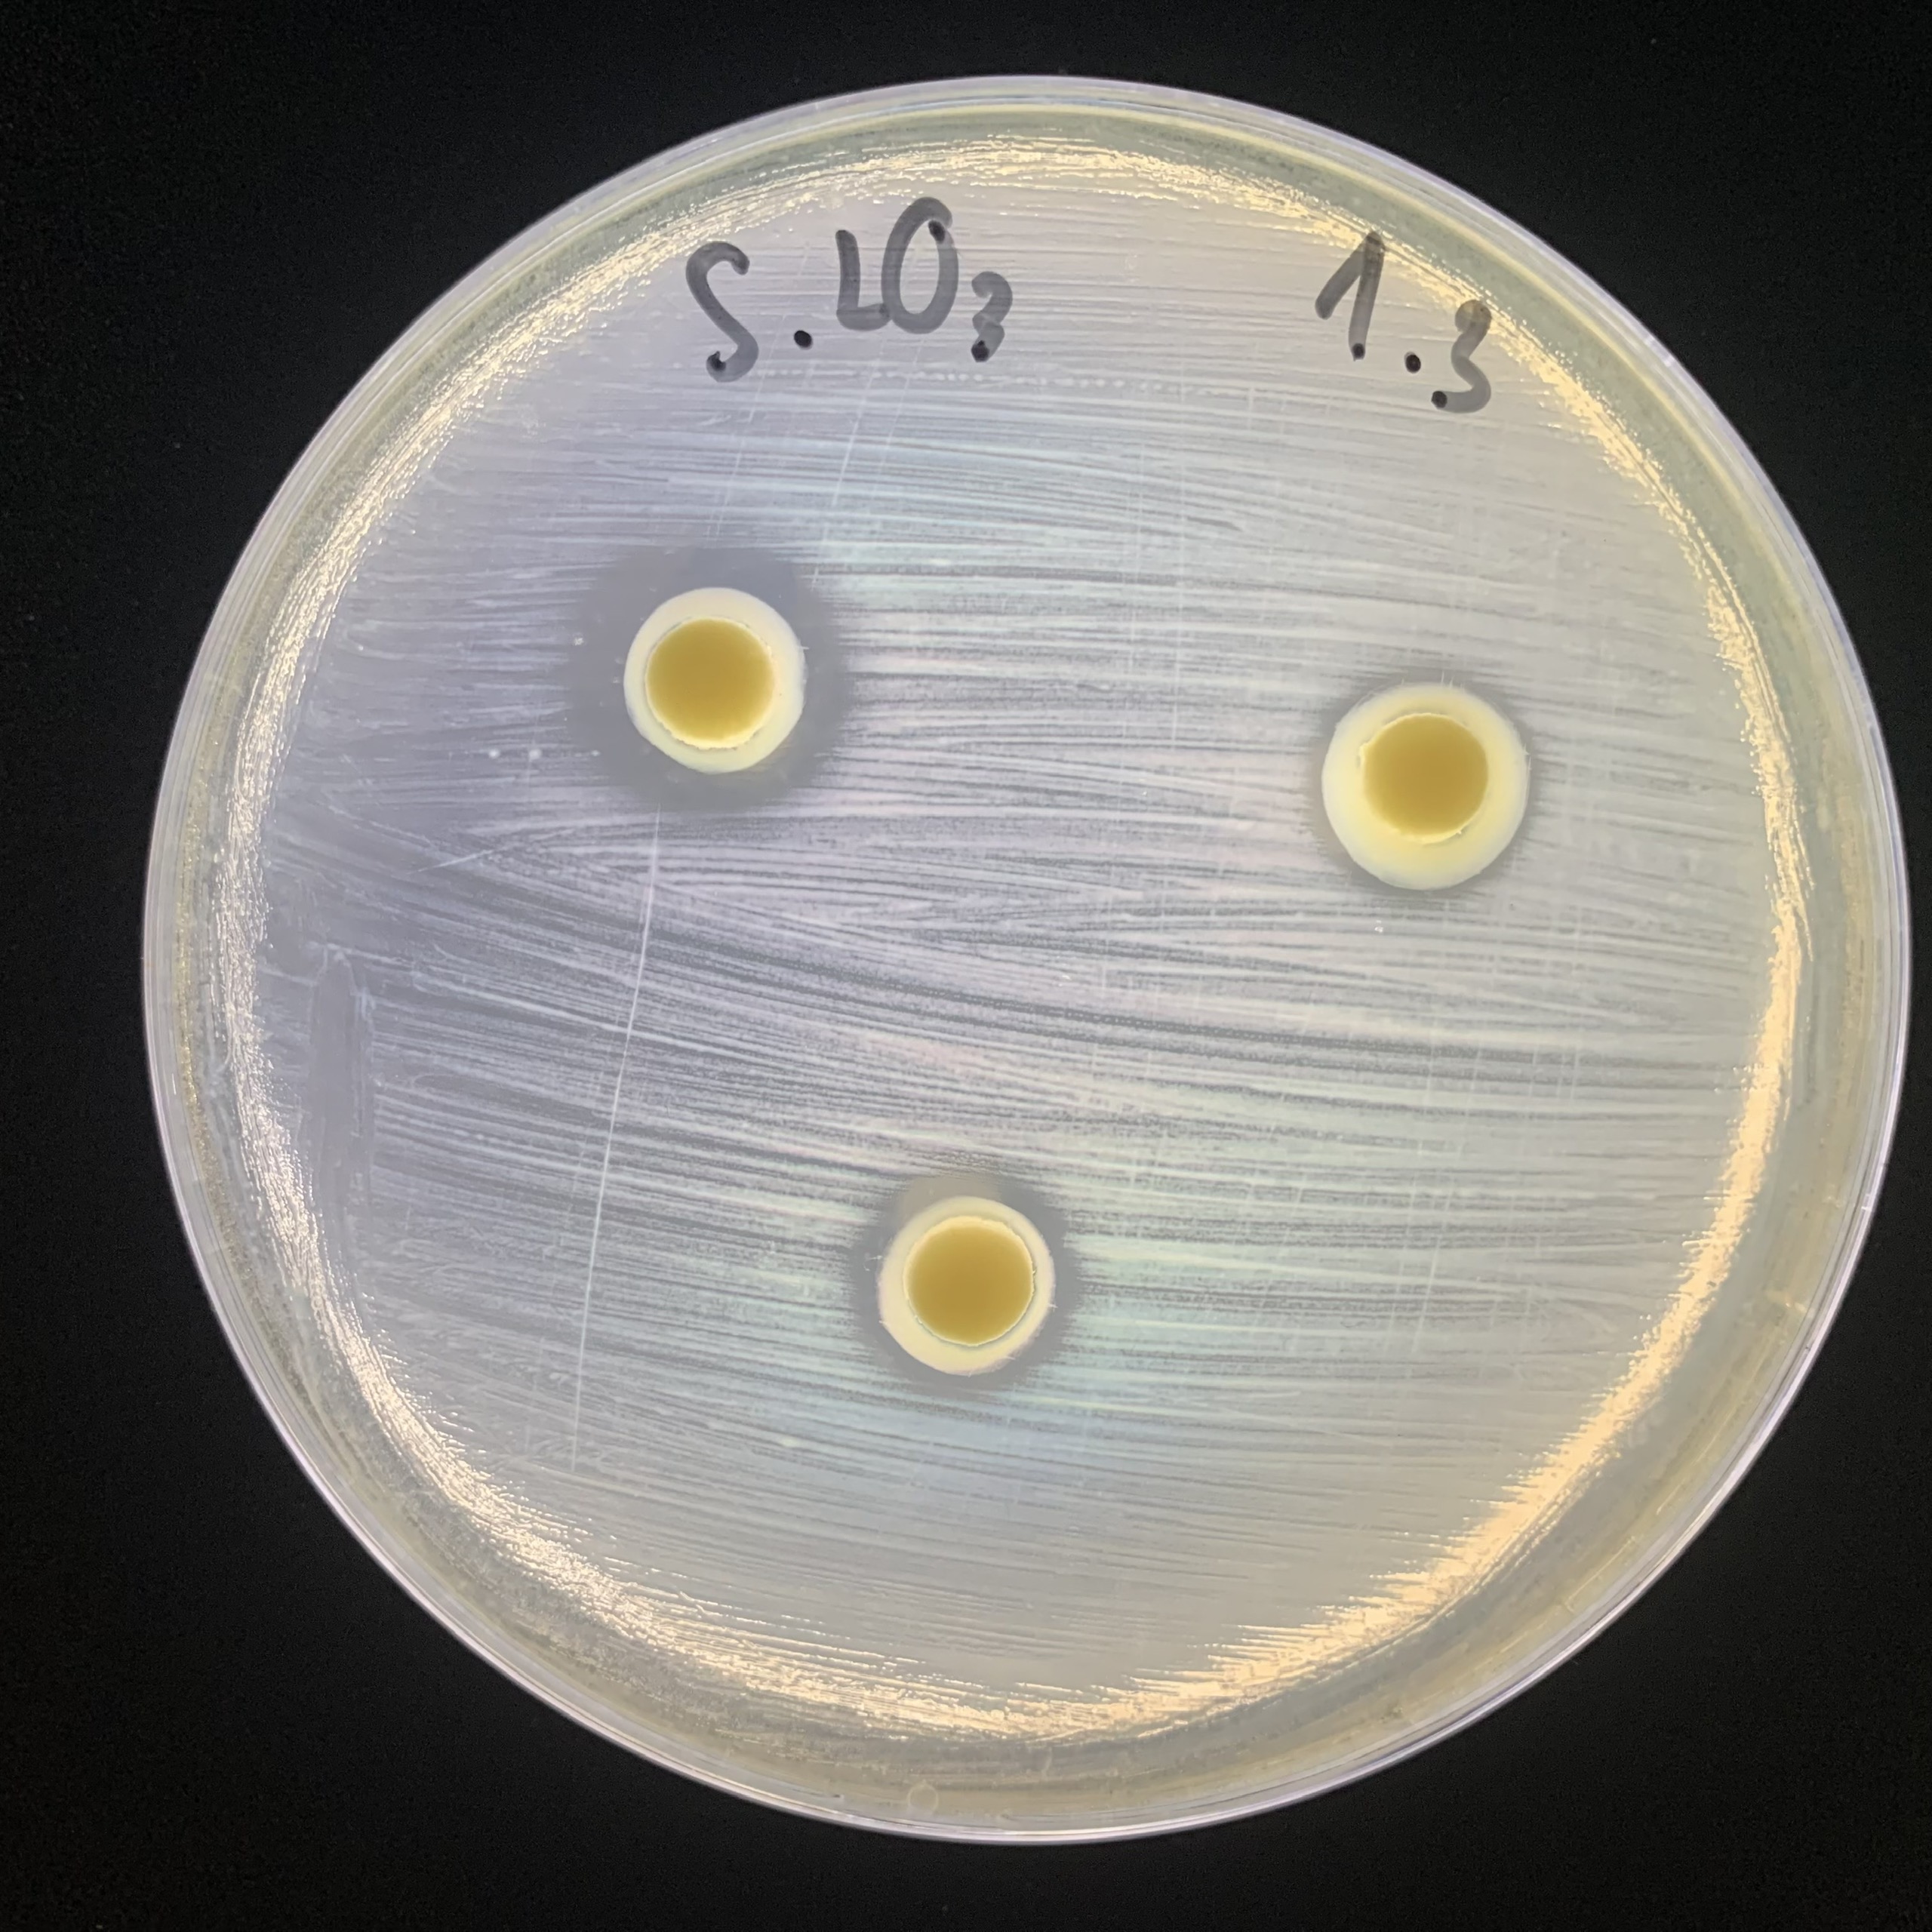
Lactobacillus acidophilus
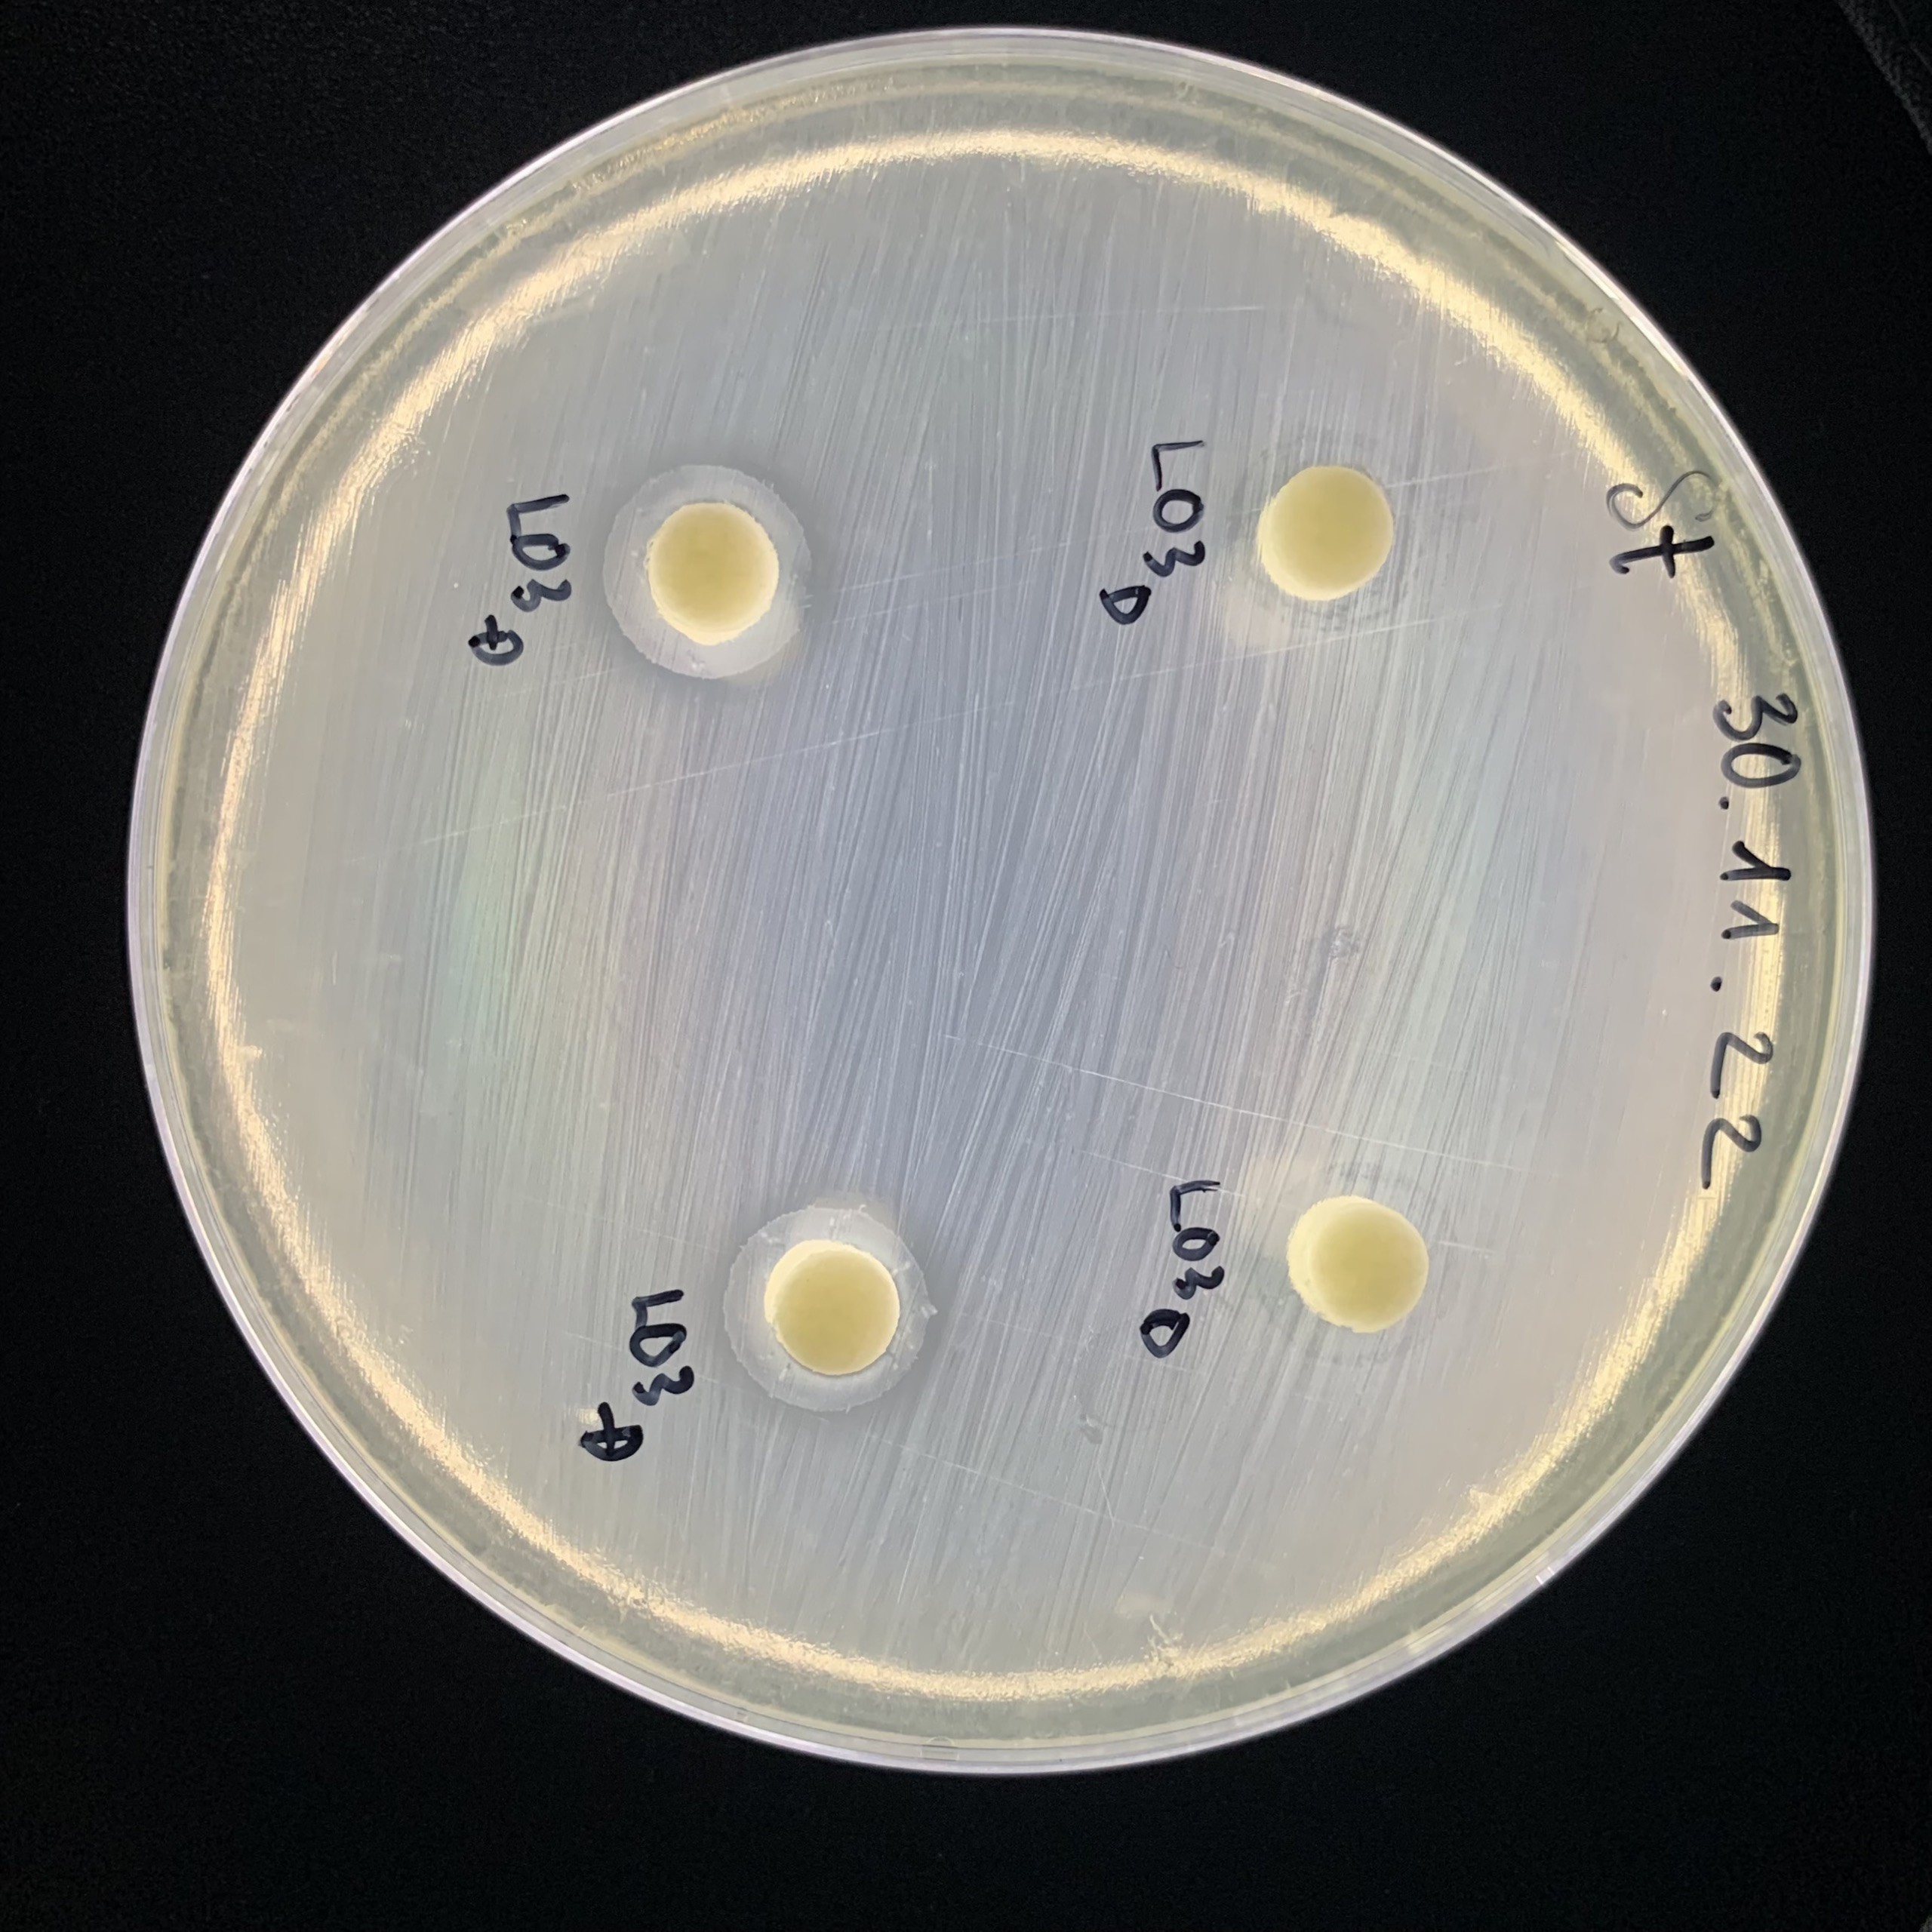
Lactobacillus plantarum
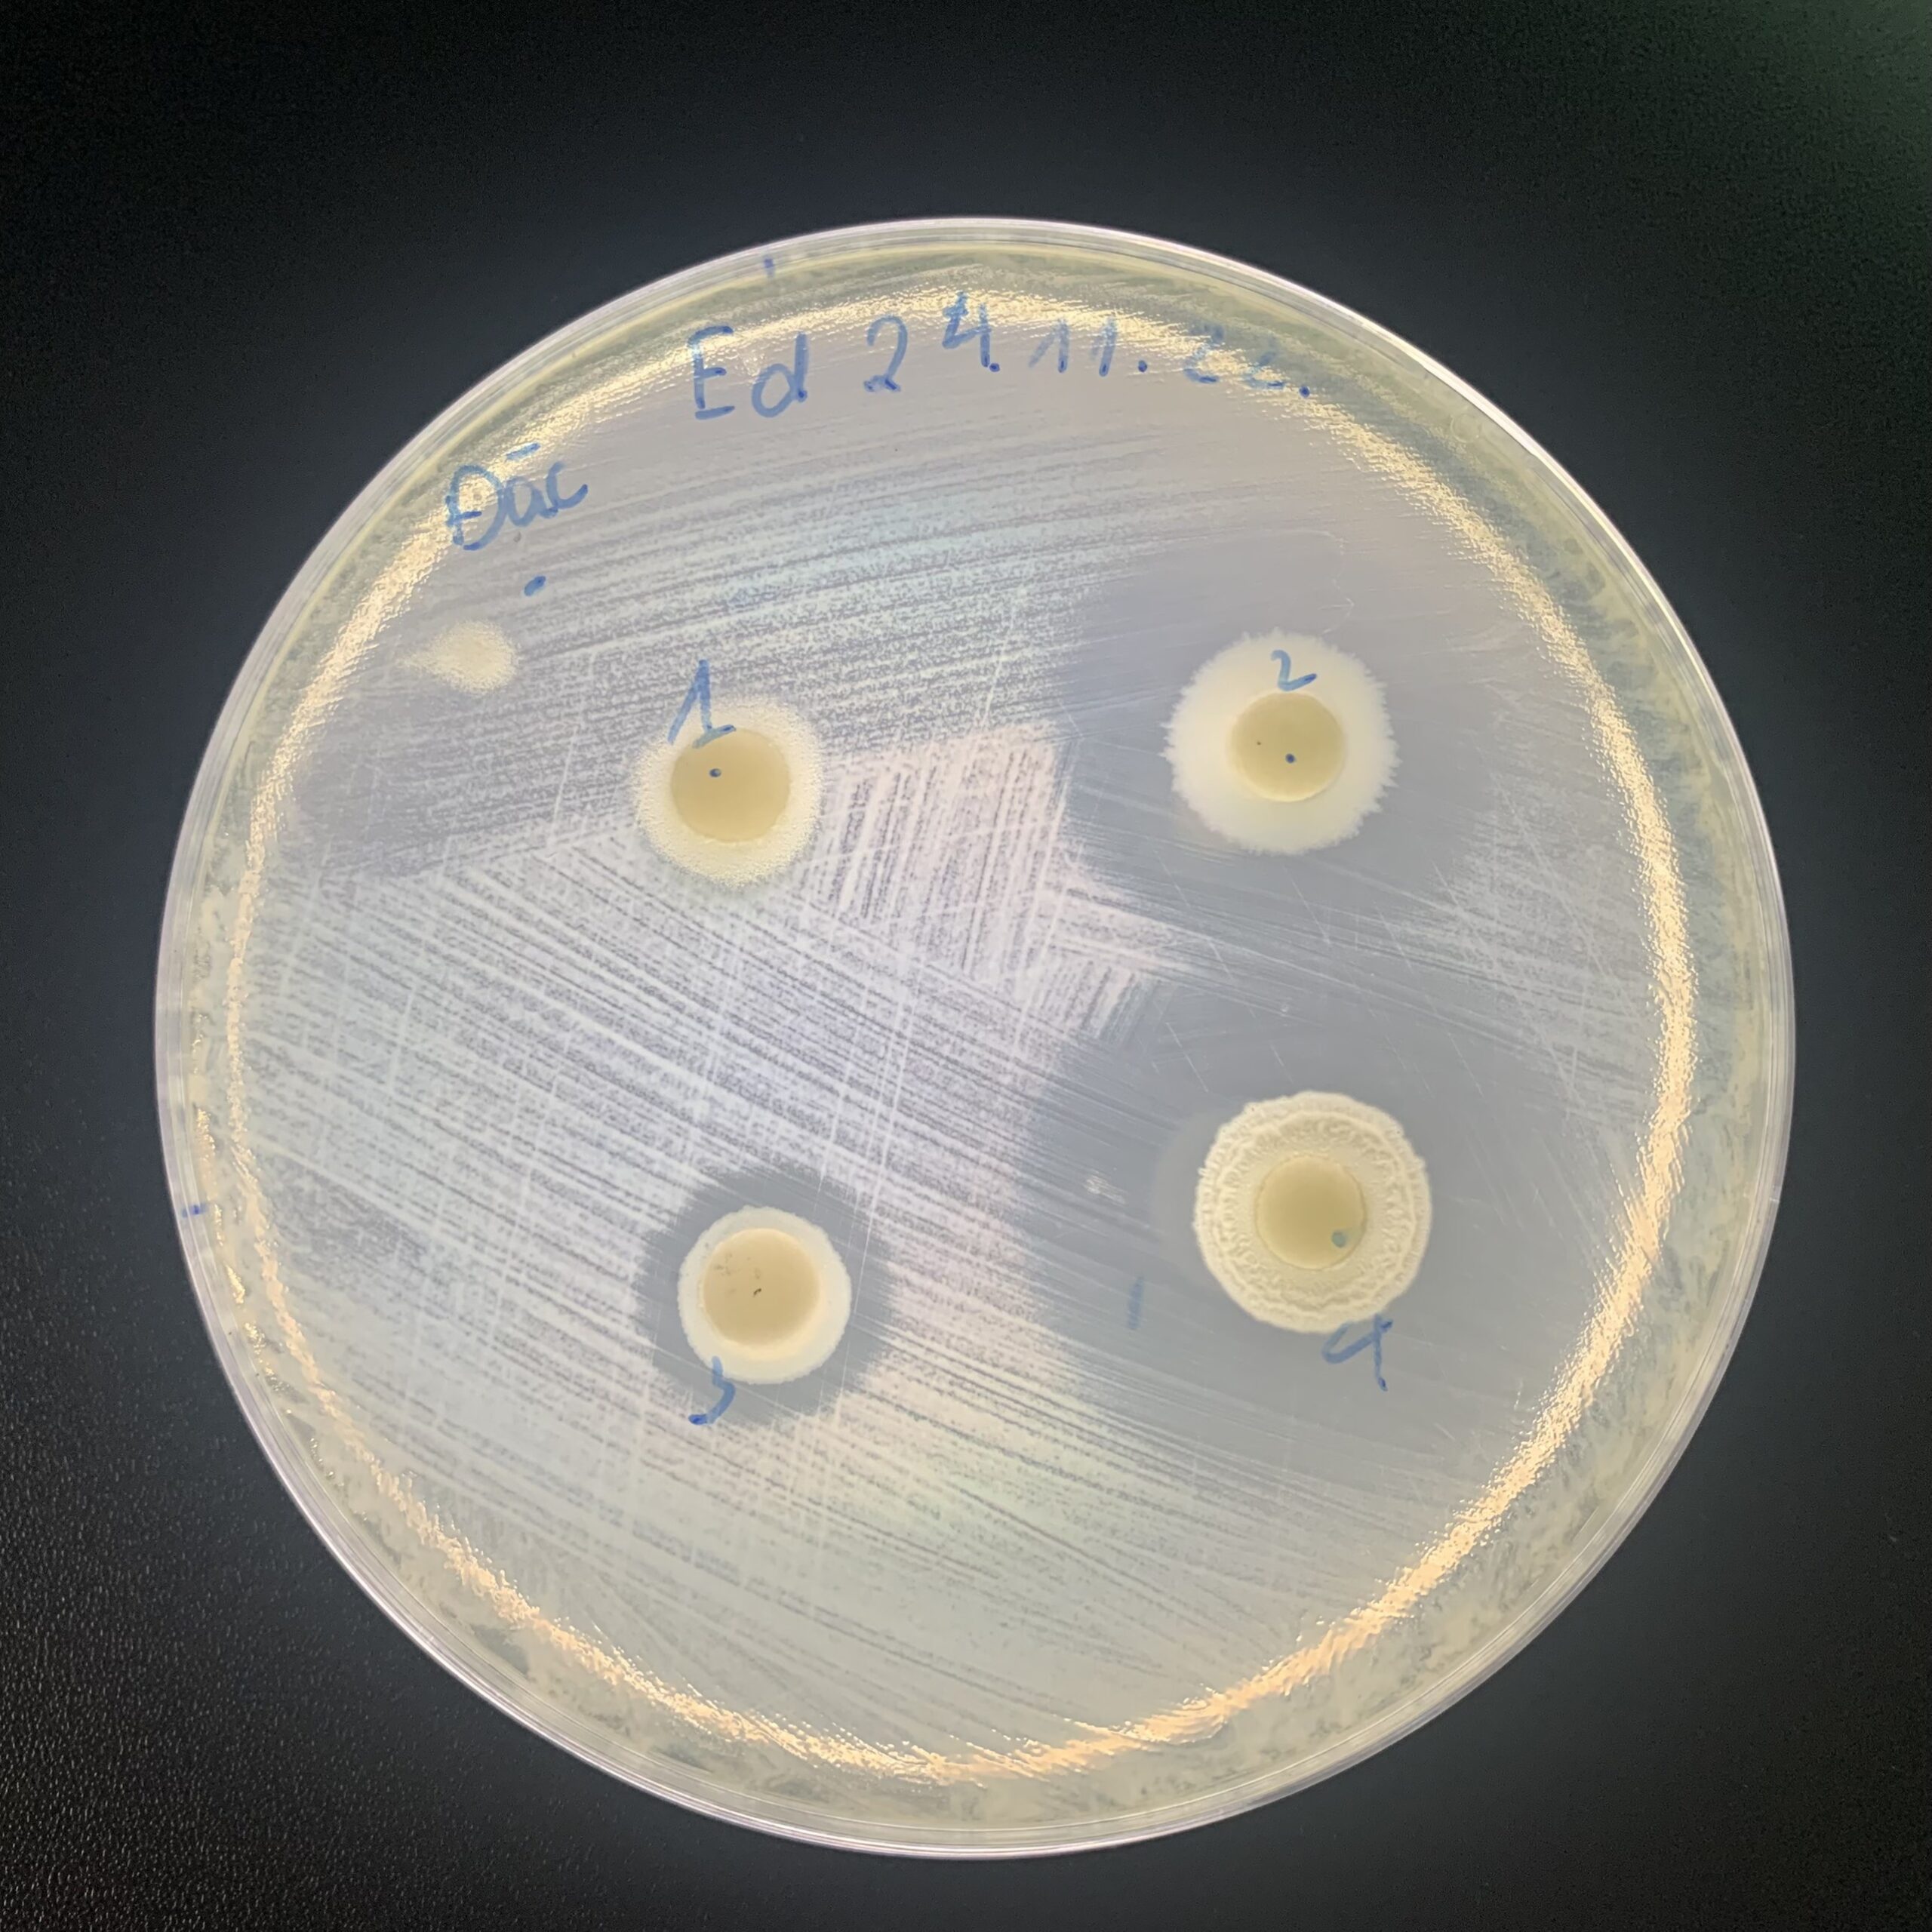
Saccharomyces cerevisiae

Bio-Floc mỗi nguyên liệu vi sinh cung ứng cho các đối tác không chỉ chứa những loài vi sinh chung chung mà nó chứa các chủng vi sinh chuyên biệt cho ứng dụng hiệu quả.
Contents
Ưu điểm nổi bật của bộ nguyên liệu vi sinh đơn chủng Bio-Floc
Nguyên liệu vi sinh đơn chủng của Bio-Floc được phân biệt đến từng chủng chứ không chỉ đến loài; nguyên liệu vi sinh đơn chủng của Bio-Floc được sản xuất từ các chủng vi sinh tuyển chọn theo hoạt tính sinh học để ứng dụng hiệu quả chứ không chỉ là sinh khối vi sinh. Do đó, nguyên liệu vi sinh đơn chủng của Bio-Floc có ưu điểm:
- Khả năng sinh enzyme ngoại bào mạnh mẽ – hỗ trợ phân hủy nhanh chất hữu cơ, tăng hiệu suất xử lý sinh học.
- Ức chế mạnh mầm bệnh – giúp kiểm soát mầm bệnh, giảm nguy cơ mắc bệnh của vật nuôi, tăng hiệu quả sản xuất.
- Phát triển tốt với thay đổi của môi trường, mô hình nuôi…– hoạt động ổn định ở dải nhiệt độ, pH và độ mặn cao.

Nhờ đó, các nhà máy sản xuất chế phẩm sinh học, phụ gia chăn nuôi, thủy sản, và xử lý môi trường có thể dễ dàng ứng dụng, phối trộn và phát triển các sản phẩm vi sinh chuyên biệt với hiệu quả vượt trội.
Quy trình bảo quản và sản xuất hiện đại – chuẩn quốc tế
Toàn bộ quy trình nghiên cứu, bảo quản và sản xuất chủng vi sinh tại Bio-Floc được thực hiện trên hệ thống dây chuyền hiện đại, ứng dụng các công nghệ tiên tiến hàng đầu thế giới, đảm bảo độ tinh khiết, ổn định và hoạt tính sinh học cao nhất:
- Bảo quản chủng giống ở -80°C trên thiết bị chuyên dụng, duy trì tính ổn định và chất lượng chủng gốc lâu dài.
- Nhân sinh khối tự động trên hệ thống lên men với thông số kỹ thuật được cài đặt riêng cho từng chủng vi sinh.
- Cô đặc sinh khối 30–50 lần bằng công nghệ lọc tiếp tuyến, tăng mật độ tế bào mà không gây tổn thương cấu trúc.
- Ứng dụng song song hai công nghệ làm khô tiên tiến nhất:
- Đông khô ở -50°C – giữ nguyên hoạt tính sinh học của các chủng không sinh bào tử.
- Phun sấy tầng sôi – tăng độ ổn định và kéo dài thời gian bảo quản của sản phẩm.

Nhờ hệ thống công nghệ khép kín và kiểm soát nghiêm ngặt, mỗi chủng vi sinh của Bio-Floc luôn đạt độ tinh khiết cao, hoạt tính ổn định và độ bền vượt trội.
Danh mục nguyên liệu vi sinh đơn chủng Bio-Floc
Bio-Floc hiện đang sản xuất và cung ứng bộ nguyên liệu vi sinh đơn chủng đạt tiêu chuẩn quốc tế, phù hợp cho sản xuất chế phẩm sinh học, phụ gia chăn nuôi, thủy sản, phân bón vi sinh, xử lý nước và môi trường.
1. Bacillus subtilis

Chủng vi sinh có khả năng sinh enzyme ngoại bào mạnh mẽ (amylase, protease, lipase), giúp phân hủy nhanh chất hữu cơ, giảm khí độc trong ao nuôi và tăng hiệu quả tiêu hóa khi bổ sung vào thức ăn.
Mật độ cung ứng: Mật độ: 1.0 x 1010 cfu/gram
👉 Ứng dụng: sản xuất chế phẩm xử lý nước, enzyme, men tiêu hóa và probiotic cho vật nuôi.
2. Bacillus clausii
Là chủng có khả năng kháng khuẩn mạnh và bền nhiệt cao, giúp ổn định đường ruột, ức chế vi sinh vật gây bệnh, đặc biệt hiệu quả trong điều kiện nhiệt độ và pH khắc nghiệt.
Mật độ cung ứng:Mật độ: 1.0 x 1010 cfu/gram
👉 Ứng dụng: sản xuất men vi sinh đường ruột, chế phẩm tăng sức đề kháng cho vật nuôi.
3. Bacillus licheniformis
Chủng có khả năng sinh protease và kháng sinh tự nhiên (bacitracin), hỗ trợ phân giải protein, ức chế mầm bệnh và thúc đẩy tăng trưởng vật nuôi.
Mật độ cung ứng: Mật độ: 1.0 x 1010 cfu/gram
👉 Ứng dụng: sản xuất thức ăn bổ sung, enzyme sinh học, xử lý môi trường chăn nuôi – thủy sản.
4. Bacillus amyloliquefaciens
Chủng nổi bật với hoạt tính enzyme amylase, cellulase và xylanase cao, có tác dụng phân rã tinh bột, chất xơ và mùn bã hữu cơ nhanh chóng.
Mật độ cung ứng: Mật độ: 2.0 x 1010 cfu/g
👉 Ứng dụng: sản xuất chế phẩm xử lý đáy ao, giảm mùn bã, và cải thiện hệ tiêu hóa cho tôm cá.
5. Lactobacillus acidophilus
Chủng vi sinh sinh acid lactic tự nhiên, giúp ức chế vi khuẩn gây bệnh, cân bằng hệ vi sinh đường ruột và cải thiện khả năng hấp thu dinh dưỡng.
Mật độ cung ứng: Mật độ: 2.0 x 1010 cfu/g
👉 Ứng dụng: men vi sinh đường ruột, probiotic trong thức ăn chăn nuôi và nuôi trồng thủy sản.
6. Lactobacillus plantarum
Chủng chịu mặn, chịu nhiệt tốt, có khả năng tạo acid lactic nhanh và ổn định hệ vi sinh trong môi trường nước.
Mật độ cung ứng: Mật độ: 2.0 x 1010 cfu/g
👉 Ứng dụng: chế phẩm ổn định môi trường ao nuôi, men tiêu hóa, probiotic bảo vệ đường ruột.
7. Saccharomyces cerevisiae
Là nấm men vi sinh có hoạt tính sinh học cao, giàu vitamin nhóm B và enzyme, giúp kích thích tiêu hóa, tăng miễn dịch và hấp thu dinh dưỡng.
Mật độ cung ứng: Mật độ: 1.0 x 1010 cfu/gram
👉 Ứng dụng: men tiêu hóa, chế phẩm tăng cường miễn dịch và chất xúc tác sinh học trong sản xuất enzyme.
Tất cả các nguyên liệu vi sinh Bio-Floc đều được:
- Cung cấp kèm hồ sơ kỹ thuật và phiếu kiểm nghiệm đầy đủ,
- Kiểm soát chất lượng chặt chẽ theo tiêu chuẩn phòng R&D của Bio-Floc,
- Đảm bảo tính thuần chủng, ổn định hoạt tính và tương thích với điều kiện sản xuất tại Việt Nam.
Đội ngũ R&D chuyên sâu của Bio-Floc luôn sẵn sàng đồng hành cùng các nhà máy, nghiên cứu và phát triển công thức sản phẩm độc quyền, tối ưu theo mục tiêu và lĩnh vực ứng dụng của từng đối tác.
Với năng lực chủ động nguồn giống – công nghệ sản xuất – hệ thống kiểm định nội bộ, Bio-Floc cam kết mang đến giải pháp vi sinh chuyên sâu, hiệu quả và bền vững nhất cho mọi doanh nghiệp.



